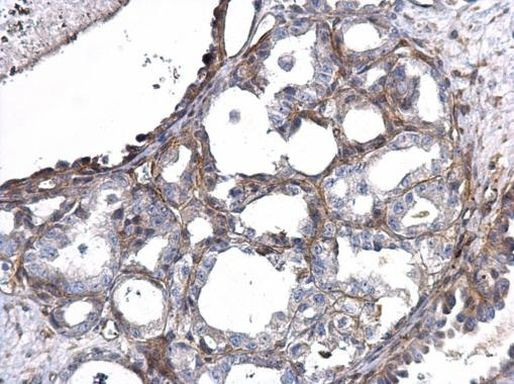
MMP14 Antibody in Immunohistochemistry (Paraffin) (IHC (P))

Search
Invitrogen
MMP14 Polyclonal Antibody
{{$productOrderCtrl.translations['antibody.pdp.commerceCard.promotion.promotions']}}
{{$productOrderCtrl.translations['antibody.pdp.commerceCard.promotion.viewpromo']}}
{{$productOrderCtrl.translations['antibody.pdp.commerceCard.promotion.promocode']}}: {{promo.promoCode}} {{promo.promoTitle}} {{promo.promoDescription}}. {{$productOrderCtrl.translations['antibody.pdp.commerceCard.promotion.learnmore']}}
产品信息
PA5-34643
宿主/亚型
分类
类型
抗原
偶联物
形式
浓度
保存条件
运输条件
产品详细信息
IHC notes, Requires antigen retrieval using heat mediated 10mM Citrate buffer (pH6.0) or Tris-EDTA buffer (pH8.0)
靶标信息
Proteins of the matrix metalloproteinase (MMP) family are involved in the breakdown of extracellular matrix in normal physiological processes, such as embryonic development, reproduction, and tissue remodeling, as well as in disease processes, such as arthritis and metastasis. Most MMP's are secreted as inactive proproteins which are activated when cleaved by extracellular proteinases. However, the protein encoded by this gene is a member of the membrane-type MMP (MT-MMP) subfamily; each member of this subfamily contains a potential transmembrane domain suggesting that these proteins are expressed at the cell surface rather than secreted. This protein activates MMP2 protein, and this activity may be involved in tumor invasion.
⚠WARNING: This product can expose you to chemicals including mercury, which is known to the State of California to cause birth defects or other reproductive harm. For more information go to www.P65Warnings.ca.gov.
仅用于科研。不用于诊断过程。未经明确授权不得转售。